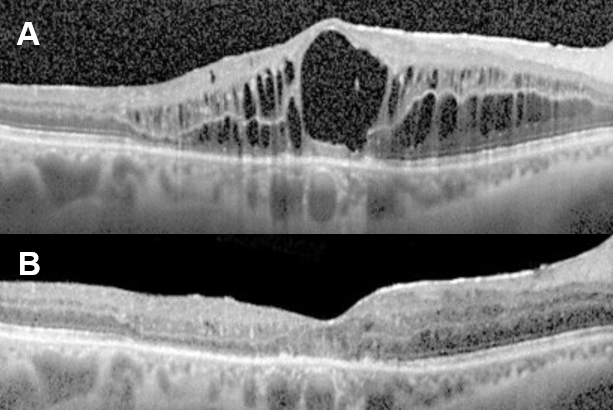

지난 시간에 이어서 ‘낭포황반부종(Pseudophakic Cystoid Macular Edema; CME)’ 2화입니다.백내장 수술을 했는데 더 보이지 않아요. 수술이 잘못된 건가요? 결론부터 말하면 ‘백내장 수술’이 잘…blog.naver.com 진단 방법까지 살펴봤습니다.오늘은 치료 방법에 대해서 공부하겠습니다.1) 약물치료
- 부신피질호르몬제(스테로이드, Corticosteroid): ‘단기간 효과’는 분명하지만 ‘장기간’ 사용 시 부작용에 항상 주의해야 합니다.① 작용 원리γ 인지질분해효소(Phospholipase) A2를 억제하고 염증성 매개 물질인 ‘프로스타글란딘(Prostaglandin; PG)’ 생성을 감소시킵니다.㉡ 대식세포와 중성 백혈구의 이동을 억제하고 모세혈관 투과성과 혈관 확장도 감소시킵니다.② 국소 점안 스테로이드(안약): 첫 번째 치료제로 고려합니다.③ 눈 주위 주사(그림 1): 안약 치료 후 재발하는 CME에 사용합니다. 유리체강내 주사보다 부작용이 적습니다.

그림 1. (A)테논난하트리암시놀론(Sub-Tenon Triamcinolone) 주입술, (B) 주사 전 CME, (C) 주사 2개월 후 호전-중심 오목 형태가 유지 중 ④ 유리체강 내 주사 ⑤ 트리암시놀론(Triamcinolone, 그림 2-A) : 혈액망막 장벽(Blood Retinal Barrier; BRB) 파괴를 감소시킵니다.* 재발성 CME에 유용하지만 효과가 일시적이기 때문에 일정 기간이 지나면 재발합니다. →효과를 유지하기 위해서는 여러 번 주사를 맞아야 합니다.㉡ 덱사메타손 삽입물(Dextamethasoneimplant; Ozurdex®, 그림2-B&C): 보다 효과가 오래 유지되지만 여전히 재발로부터 자유롭지 못합니다.

그림2.(A) 유리체강내 트리엄시놀론주입, (B)덱사메타손삽입술장면, (C)삽입된 덱사메타손인플랜트(오더덱스)의 유리체강내 모습
그림 3.(A) 주사 전 CME, (B) 덱사메타손 플랜트 삽입술 후 6개월 – 호전된 CME ᅥᆫ시 投与 전신 투여 – 먹는 약 또는 정맥 주사 : 부작용 위험이 크므로 주의하십시오.
2) 비스테로이드성 항염증제(Nonsteroidal Anti-Inflammatory Drugs;NSAIDs) ① 작용 원리: Cyclooxygenase(COX) 활동을 막고 프로스타글란딘(PG) 합성을 억제합니다.② 국소(점안) 용법: 눈 안 침투력이 강해 전신적인 부작용이 적고 우선적으로 사용합니다.* 스테로이드 안약과 함께 사용: 병용하지 않으면 약 50%에서 재발한다는 보고가 있습니다.③ 브로낙(Bromfenac, 대준제약), 아큐베일(Ketorolac, 엘러간), 옵태낙(Diclofenac, 삼일제약-삼일 외에도 디크로페낙 약제는 여러 회사에서 만듭니다) 등의 안약이 있습니다(그림 4).

그림 4. 비스테로이드성 항염증 점안제 – 스테로이드 점안제와 함께 사용합니다.3) 탄산탈수효소억제제(Carbonic Anhydrase Inhibitors; CAIs) ① 망막내 또는 망막하의 삼출물을 망막색소상피(RPE)외로 보내는 펌프의 역할 – 재발성 CME에 효과가 있습니다.② 주로 먹는 약으로 사용합니다.- 아세타졸정(Acetazolamide) 등
4) 항혈관 내피성장인자(Anti Vascular Endothelial Growth Factor; Anti-VEGF): 다른 약물에 반응하지 않는 CME에 사용할 수 있지만 아직 연구가 필요합니다.① 작용 원리: 혈액망막 장벽(BRB)을 강화하여 혈관 투과성 감소 → 부종 감소 Anti-VEGF에 대해서는 자세히 다룬 포스팅이 있으니 참고하시기 바랍니다.지난 2편의 포스팅에서 삼출성(습성) 연령관련 황반변성(WetARMD)이란 무엇인지 어떤 증상과 소견을… blog.naver.com2. 수술적 치료
- 레이저 유리체 융해술(Nd:YAG Vitreolysis) – 네오디뮴 야그레이저를 이용하여 절개창에 낀 유리체를 풀어주는 시술입니다(그림 5).

그림 5. (A)절개창에 끼워져 있는 유리체(Vitreous incarceration, Vitreous winksyndrome), (B)야그레이저 광원에 끼워져 있는 절개창을 조준하였으며, (C)야그레이저 조사 후 절개창에 끼워져 있던 유리체는 풀렸습니다.2) 유리체절제술(그림6) ① 절개창(창상) 내 또는 홍채와의 유착된 유리체 제거 ② 기존 유리체 제거 → 염증매개물질이 포함되어 있던 유리체를 제거함으로써 염증반응 감소 + 눈 깊은 내부로 약물 침투를 좋게 할 수 있습니다.③ 수술은 CME가 2개월 이상 지속됐을 때 시도해 볼 수 있지만 수술 자체가 가진 위험성과 수술 후에도 시력 호전이 없을 수도 있다는 사실을 반드시 환자에게 충분히 설명해야 합니다.

그림6.(A) 수술 전 전형적인 CME의 FAG 누출을 확인할 수 있으며, (B)유리체절제술 1개월 후 실시한 FAG에서 꽃 모양누출과 시신경 부위의 누설이 확실히 줄어든 것을 알 수 있습니다.3) CME를 일으키는 인공수정체를 제거하고 다른 것으로 대체하는 방법도 있습니다.남들이 하는 백내장 수술, 하면 다들 세상이 밝아진다고 들었는데 왜 나는 잘 보이지 않을까.어떤 수술이든 부작용과 합병증은 있어요. 100% 안전한 수술이 있다면 그 질환은 수술로 해결할 수 있기 때문에 더 이상의 연구도 필요 없을 것입니다.보다 안전한 수술, 수술을 받는 사람과 하는 사람 모두에게 부담을 덜 수 있는 방향을 찾기 위해 사람들은 계속 연구하고 발전해 나갈 것입니다.그러기 위해서는 지금의 문제, 현황을 잘 알고 있는 것이 중요하다고 생각합니다. 그래서 오늘도 어려운 눈이야기를 함께 공부해 보았습니다.수고하셨습니다!
